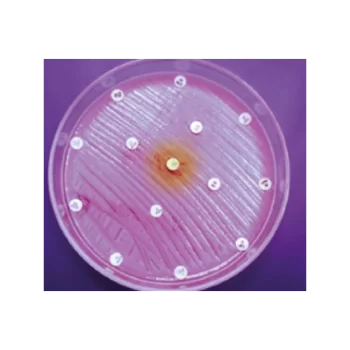

Showing 172–180 of 214 results
Oxoid™ Sulfonamide Compound Antimicrobial Sensitivity Discs / Discos para sensibilidad antimicrobiana con compuestos de sulfonamidas Oxoid™
S/ 0.00
[SKU: CT0059B]
Evalúe la sensibilidad de los microorganismos utilizando métodos AST manuales, con la ayuda de una amplia selección de discos para antibiogramas.
Oxoid™ Tetracycline Antimicrobial Susceptibility discs / Discos de susceptibilidad antimicrobiana a tetraciclina Oxoid™
S/ 0.00
[SKU: CT0054B]
Determine manualmente la susceptibilidad a los antibióticos de los microorganismos mediante métodos de prueba de susceptibilidad a los antimicrobianos (AST) junto con discos de susceptibilidad a los antimicrobianos de tetraciclina Thermo Scientific™ Oxoid™, fiables y fáciles de usar.
Oxoid™ Ticarcillin Antimicrobial Sensitivity Discs / Discos para sensibilidad antimicrobiana con ticarcilina Oxoid™
S/ 0.00
[SKU: CT0167B]
Evalúe la sensibilidad de los microorganismos utilizando métodos AST manuales, con la ayuda de una amplia selección de discos para antibiogramas.
Oxoid™ Tigecycline Antibiogram Discs / Discos para antibiogramas con tigeciclina Oxoid™
S/ 0.00
[SKU: CT1841B]
Evalúe la sensibilidad de los microorganismos utilizando métodos AST manuales, con la ayuda de una amplia selección de discos para antibiogramas.
Oxoid™ Vancomycin Antimicrobial Susceptibility discs / Discos de susceptibilidad antimicrobiana a la vancomicina Oxoid™
S/ 0.00
[SKU: CT0058B]
Determine manualmente la susceptibilidad a los antibióticos de los microorganismos utilizando métodos de prueba de susceptibilidad a los antimicrobianos (AST) junto con discos de susceptibilidad a los antimicrobianos Thermo Scientific™ Oxoid™ confiables y fáciles de usar.
Oxoid™ Violet Red Bile Agar / Agar bilis rojo violeta Oxoid™
S/ 0.00
[SKU: CM0107B]
Detecte y enumere organismos coliformes en agua, alimentos y productos lácteos con el agar bilis rojo violeta Thermo Scientific™ Oxoid™ (deshidratado).
Oxoid™ Vitox Supplement / Suplemento Oxoid™ Vitox
S/ 0.00
[SKU: SR0090A]
El suplemento Oxoid Vitox se utiliza para la preparación de medio Thayer Martin y medio New York City para el aislamiento de Neisseria spp.
Oxytetracycline Glucose Yeast Extract Agar Base (Dehydrated) / Base de agar con extracto de levadura, glucosa y oxitetraciclina (deshidratada)
S/ 0.00
[SKU: CM0545B]
Enumere selectivamente las levaduras y los mohos de los productos alimenticios con la base de agar con extracto de levadura y glucosa con oxitetraciclina (deshidratada) Thermo Scientific™ Oxoid.
Peptone Water (Dehydrated) / Agua peptona (deshidratada)
S/ 0.00
[SKU: CM0009B]
Cultive una amplia variedad de microorganismos con el agua de peptona Thermo Scientific™ Oxoid™ (deshidratada).